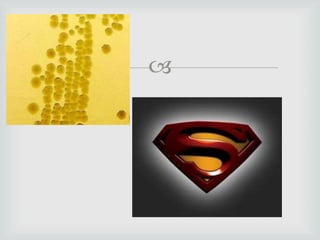


El documento presenta información sobre conceptos generales de farmacología antimicrobiana como la acción del sistema inmune, factores que alteran la respuesta inmune, farmacocinética y farmacodinamia de antibióticos. Luego se detalla sobre diferentes clases de antibióticos betalactámicos como penicilinas, cefalosporinas, carbapenemes, mecanismos de acción, resistencia, farmacocinética y efectos adversos. Finalmente se discuten aspectos particulares de algunos antibióticos representativos de